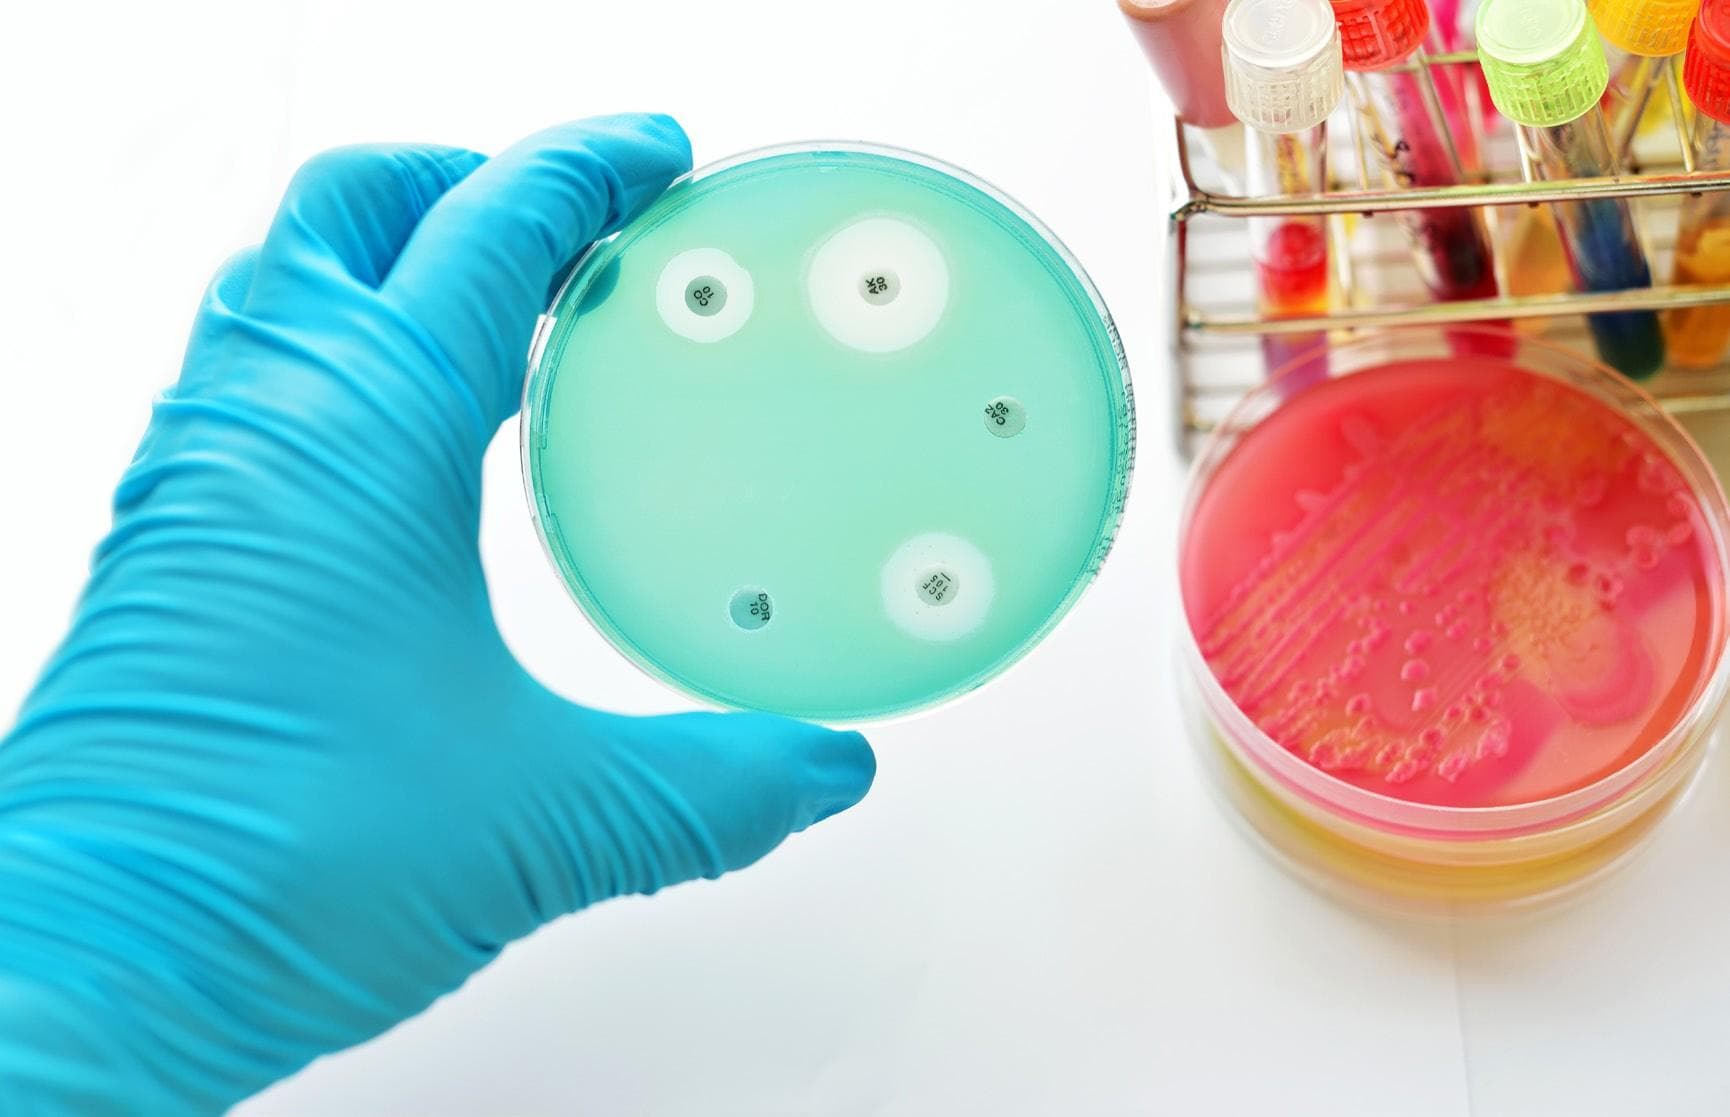
BactiVac shares development of bacterial vaccines to prevent infections against AMR

39 articles from this collection:

Janssen and Sanofi partner for E. coli vaccine programme
Janssen Pharmaceuticals, a Johnson & Johnson company, has announced a development and commercialisation agreement with Sanofi for Janssen’s extraintestinal pathogenic escherichia coli investigational vaccine programme.

PMEA
PMEA

Sun Pharma’s NDA for deuruxolitinib accepted by FDA
India-based pharma company Sun Pharmaceutical Industries has announced that the US Food and Drug Administration (FDA) has accepted its new drug application (NDA) for deuruxolitinib for the treatment of adults with moderate-to-severe alopecia areata.

SAMEDAN
Samedan

Contents
Read on for the latest news and fascinating articles

Comment
Considering health inequalities and digital therapeutics

Pharmafocus
Pharmafocus

FDA accepts Regeneron and Sanofi’s sBLA for Dupixent for priority review
Regeneron Pharmaceuticals and Sanofi have announced that the US Food and Drug Administration (FDA) has accepted their supplemental biologics license application for Dupixent (dupilumab) for the treatment of children between one and 11 years old with eosinophilic oesophagitis (EOE).

Karuna Therapeutics’ NDA submitted to FDA for schizophrenia treatment
Karuna Therapeutics has announced that it has submitted a new drug application (NDA) to the US Food and Drug Administration (FDA) for Karxt (xanomeline-trospium) for the treatment of schizophrenia.

$175m raised by Avalyn Pharma in Series C financing for inhalation therapies
US-based clinical stage biopharmaceutical company Avalyn Pharma has announced that it has raised $175m in series c financing to continue its portfolio of inhalation therapies.

€45m series B funding raised by Acesion Pharma
Acesion Pharma has announced that it has closed an oversubscribed €45m series b financing round.

Genentech announces results from two phase 3 trials of retinal vein occlusion treatment
Genentech has announced positive topline long-term results from its global phase 3 BALATON and COMINO trials, which assessed extended treatment intervals with Vabysmo (faricimab-svoa) in macular oedema due to branch and central retinal vein occlusion (BRVO and CRVO).

Sanofi announces long-term efficacy data for Nexviazyme for Pompe disease treatment
Sanofi has shared new data for the long-term efficacy of Nexviazyme (avalglucosidease alfa) for the treatment of Pompe disease at the 28th annual congress of the world muscle society (WMS) in Charleston, South Carolina, US.

INTERNATIONAL CLINICAL RESEARCHER
Www.pharmatimes.com/intcr

Moderna announces clinical trial results for combination flu and COVID-19 vaccine
Moderna has announced positive interim results from the phase 1/2 trial of mRNA-1083, its investigational combination vaccine against influenza and COVID-19.

AstraZeneca & Daiichi Sankyo share results from phase 3 trial for breast cancer treatment
AstraZeneca and Daiichi Sankyo have shared positive high-level results from the tropion-breast01 phase 3 trial, which showed datopotamab deruxtecan (dato-dxd) demonstrating a statistically significant and clinically meaningful improvement in progression-free survival (pfs) compared to chemotherapy in patients with inoperable or metastatic hormone receptor (hr)-positive, her2-low or negative breast cancer.

Biogen’s Tofidence biosimilar gains FDA approval
Biogen has announced that the FDA has approved Tofidence (tocilizumab-bavi) as an intravenous formulation, a biosimilar monoclonal antibody referencing actemra.

New vaccine for prevention of malaria in paediatric patients recommended by WHO
The World Health Organization (WHO) has announced that it has recommended a new vaccine, r21/matrix-m, for the prevention of malaria in children.

Pfizer’s RSV vaccine provisionally recommended by CDC Advisory Committee
Pfizer has announced that the US Centers for Disease Control and Prevention’s (CDC) Advisory Committee on Immunization Practices (ACIP) has recommended abrysvo, the company’s bivalent respiratory syncytial virus (RSV) vaccine, for maternal immunisation.

Eli Lilly and Boehringer Ingelheim’s Jardiance approved by FDA for chronic kidney disease treatment
Eli Lilly and Boehringer Ingelheim have announced that the FDA has approved Jardiance (empagliflozin) 10mg tablets to reduce risk of sustained decline in estimated glomerular filtration rate (EGFR), end-stage kidney disease, cardiovascular death and hospitalisation in adults with chronic kidney disease (CKD).

GSK and Zhifei announce partnership for promotion of shingles vaccine in China
GSK has announced that it has come to an exclusive agreement with Chingqing Zhifei biological products to co-promote GSK’s shingles vaccine, Shingrix, in China for an initial three years, with the option to extend the partnership further.

Sanofi and Teva announce partnership for development of inflammatory bowel disease treatment
Sanofi and Teva Pharmaceuticals have announced that they will collaborate for the co-development and co-commercialisation of TEV’574, a treatment for ulcerative colitis (UC) and crohn’s disease, currently in phase 2b clinical trials.

Innovations in Pharmaceutical Technology
Www.iptonline.com

DNA test for predisposition to certain cancers granted marketing authorisation by FDA
The US Food and Drug Administration (FDA) has granted de novo marketing authorisation to the invitae common hereditary cancers panel, which is an in vitro diagnostic test to detect hundreds of genetic variations associated with risk of developing certain cancers.
BactiVac shares development of bacterial vaccines to prevent infections against AMR
The University of Birmingham, UK hosted bacterial vaccines network has been awarded £1.4m in funding from the UK government to accelerate the development of bacterial vaccines in the fight against antimicrobial resistance (AMR).

Mirati Therapeutics to be acquired by BMS for $4.8bn
Bristol Myers Squibb (BMS) and Mirati Therapeutics have announced that they have entered into a definitive agreement under which BMS will acquire Mirati for $58 per share, or a total value of $4.8bn.

POINT Biopharma to be acquired by Eli Lilly for $1.4bn
Eli Lilly and POINT Biopharma have announced a definitive agreement for Lilly to acquire POINT to expand its pipeline of clinical and preclinical-stage radioligand therapies for the treatment of cancer.

Alfasigma acquires Intercept Pharmaceuticals for approximately $800m
Alfasigma and Intercept Pharmaceuticals have announced that they have entered into a definitive merger agreement, meaning Alfasigma will acquire Intercept for $19 per share.

SAMEDAN
Www.samedanltd.com

The role of digital therapeutics in central nervous system clinical trials
Louisa Steinberg and Maureen Glynn from ICON consider the role of digital therapeutics in the treatment of central nervous system conditions and how they can be used to improve clinical trials

From the Margins: a book review
Betsy Goodfellow from Pharmafocus reviews Gilead’s innovative new book, From the Margins. Described as ‘the most difficult book to read’, it highlights stories of hardship, stigmatisation, abuse and marginalisation

#PharmaRole
Pharmarole.com

Konstantinos Vlassis appointed as Closed Loop Medicine’s chief technology officer
Closed Loop Medicine has announced the appointment of Konstantinos Vlassis as chief technology officer.

FUJIFILM Diosynth Biotechnologies appoints Maja Pedersen as chief quality officer
CEO and president of FUJIFILM Diosynth Biotechnologies Lars Petersen has appointed Maja Pedersen as chief quality officer, where she will serve as a member of the executive leadership team.

Invizius appoints Bernard Canaud to clinical advisory board
Invisius Limited has announced that it has appointed Professor Bernard Canaud to its clinical advisory board.

Pheon appoints Arvin Yang as chief medical officer
Pheon Therapeutics has announced hat it has appointed Arvin Yang MD PhD as chief medical officer.

Five facts about health inequalities
Read on for five key facts about health inequalities

@Pharmafocus
Get in touch @pharmafocus

Pharmafile
Www.pharmafile.com
